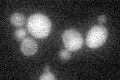
YJR094C
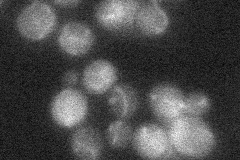
YJR094C

View description
Master regulator of meiosis that is active only during meiotic events, activates transcription of early meiotic genes through interaction with Ume6p, degraded by the 26S proteasome following phosphorylation by Ime2p
Localization:
Intensity:
Fold change:
Significance:
-
C’ GFP library in SD
below threshold18.08 -
N' NOP1pr-GFP in SD

cytosol42.9725 -
N' TEF2pr-mCherry in SD

below threshold6.06712 -
N' NATIVEpr-GFP in SD
mitochondria18.3735 -
N' TEF2pr-VC and Cyto-VN in SD

#N/A0 -
C’ GFP library in SD+DTT

cytosol15.480.85No -
C’ GFP library in SD+H2O2

cytosol16.450.9No -
C’ GFP library in Starvation Media

cytosol22.581.24No -
C’ GFP library on the background of Pup2-DaMP

below threshold -
C’ GFP library on the background of CCT mutant

below threshold19.52511.07921No
